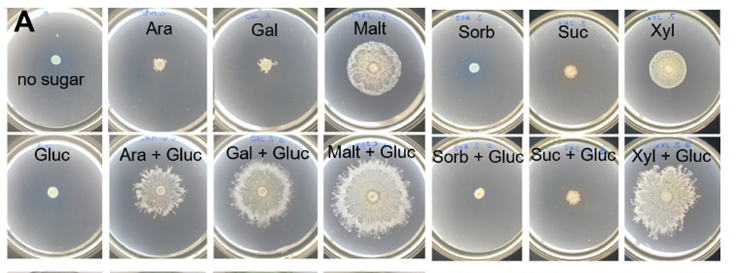
Surfeando en su propia ola: descubren un nuevo y sorprendente mecanismo de movimiento bacteriano

noviembre 2025
-

🌈 Tejiendo el Arcoíris: Bacterias que fabrican y colorean textiles en un solo paso
Por una industria de la moda libre de petróleo y de químicos tóxicos. La industria textil carga con una reputación pesada: es una de las…
-

De Punto Final a Punto y Seguido: La Terapia Genética Universal que Engaña a los Errores Fatales del ADN
Resumen Una cuarta parte de todas las enfermedades genéticas se debe a un simple “error tipográfico” en el ADN que detiene prematuramente la producción de…
-

Fatiga Cromatínica: La Cicatriz Oculta que Nuestro ADN Nunca Olvida
Resumen Nuestro ADN sufre daños constantemente, pero las células tienen sistemas notables para repararlos. Durante décadas, asumimos que, una vez que se repara una ruptura…
-

LEVA: La Impresora de Luz que Dibuja con las Partículas de la Vida
Resumen Las vesículas extracelulares (VEs) son nanopartículas que las células utilizan para comunicarse, una especie de “correo celular” que circula por el cuerpo. Hasta ahora,…
-

El Color de las Mariposas, Fabricado por una Superbacteria Reprogramada
Resumen Los colores vibrantes de la naturaleza, como los de las alas de una mariposa, provienen de pigmentos complejos como la xantomatina, una molécula con…
-

Lego Molecular: Científicos Construyen Virus Sintéticos para Aniquilar Superbacterias
Resumen En la carrera armamentista contra las bacterias resistentes a los antibióticos, la humanidad necesita nuevas armas. Una de las más prometedoras es la terapia…
-

El Eco Genético de la Edad de Hielo: Científicos Rescatan el ARN de Mamuts y Escuchan sus Genes por Primera Vez
Resumen Durante años, la paleogenética se ha centrado en el ADN, el manual de instrucciones de la vida. Sin embargo, el ADN no revela qué…
-

Descifrando la Gramática Oculta de las Proteínas: El Lenguaje que Gobierna la Célula
Resumen Durante décadas, hemos imaginado las proteínas como máquinas rígidas y estructuradas. Sin embargo, una gran porción del proteoma humano está compuesta por regiones “desordenadas”…

Buscar
Últimos Posts
Últimos Comentarios
Categorías
Archivos
- mayo 2026 (19)
- abril 2026 (35)
- marzo 2026 (30)
- febrero 2026 (15)
- enero 2026 (21)
- diciembre 2025 (20)
- noviembre 2025 (16)
- octubre 2025 (21)
- septiembre 2025 (17)
- agosto 2025 (17)
- julio 2025 (19)
- junio 2025 (24)
- mayo 2025 (26)
- abril 2025 (49)
- marzo 2025 (20)
- febrero 2025 (10)
- enero 2025 (7)
- diciembre 2024 (8)
- noviembre 2024 (23)
- octubre 2024 (7)
Palabras clave
Sígue las noticias
Te invitamos a registrar tus datos como tu correo electrónico para que puedas recibir las últimas noticias y anuncios de Biología Molecular México

By signing up, you agree to the our terms and our Privacy Policy agreement.